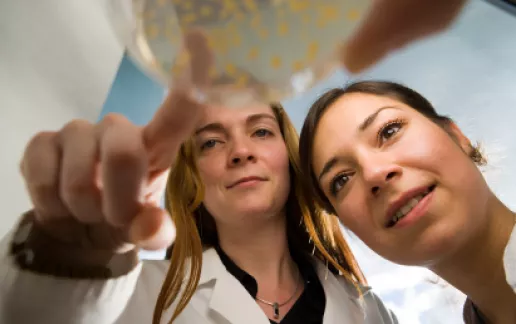
teaser corporate stipend program

Scholarship funds
Scholarship fundsConstructor University applicants come from all over the world, with about half the student body hailing from developing or emerging market countries. These diverse bright minds are socially or culturally engaged in a wide range of projects and keen to make a positive impact at home and abroad.
Scholarships allow young talents to realize their full potential in study programs which best match their profile. Donations are distributed according to certified financial need and proven performance – each scholarship holder receives precisely the support he or she requires.
Donors may support one or more of three scholarship funds:
- Support for international talents (Code: 21002)
Young people from all over the world, especially from emerging markets and developing countries – taking global and intercultural responsibility - Women in STEM disciplines (Code: 21003)
Women in Science, Technology, Engineering and Mathematics - Students with special needs (Code: 21004)
Individuals who need intensive support or logistical help because of a disability
A donation to the Constructor University Scholarship Funds is a sign of trust in the potential of the younger generation and a statement in support of open-mindedness.
For more information, please contact our Donations & Sponsoring Team.

Telephone: 0421 200 4235
Email: c.spieker@constructor.university

Telephone: 0421 200 4237
Email: c.wilkens@constructor.university